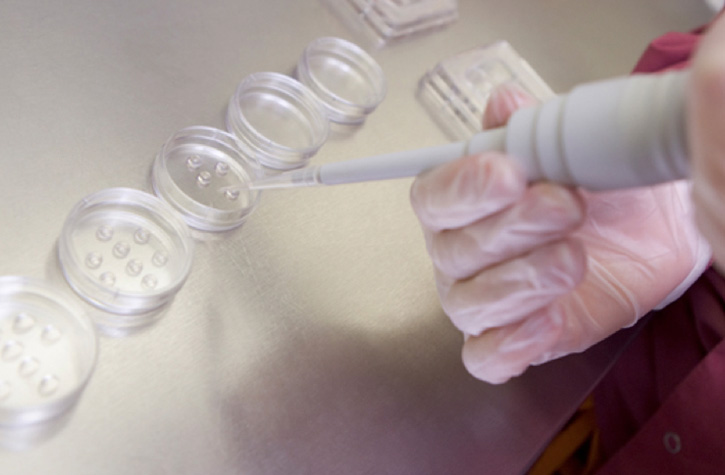
转化基因组学:生殖和遗传健康

癌症幸存者Francis和他有远见的父母,Nora and Travis,以及其他像他们一样的人是我们在帮助改善健康护理方面促进新一代测序(NGS)和芯片解决方案发展的动力。Illumina基因解决方案可以增加转化研究者对基因在疾病鉴定、病理学、预后、治疗和预防中作用的了解。

我们认为帮助转化和临床研究者从生理学新视角阐述癌症,能够对其鉴定和治疗产生有意义的影响。我们的流程解决方案能帮助研究者深入准确地分析肿瘤分子图谱,加速癌症诊断的研发进程。我们的伙伴在个体化肿瘤方面帮助推动进程。
了解更多
NGS和以芯片为基础的解决方案在生殖和医疗保健方面从多个方面促进人们作出明智的选择。这些技术将推动转化研究,能提高IVF成功率,减少侵入性检测程序并筛查遗传疾病——这仅仅是一切未来可能的开始。
了解更多


